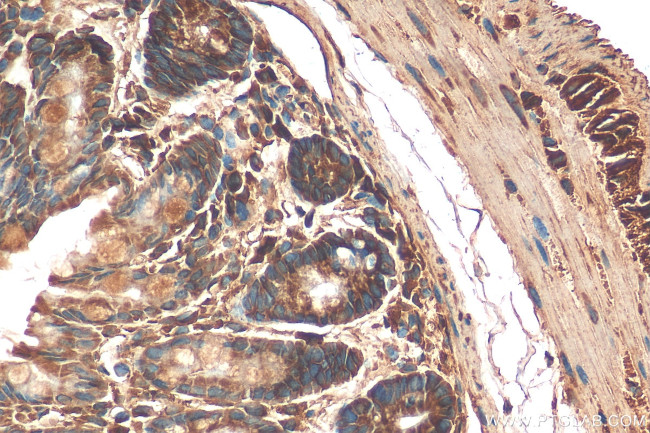
AMDHD1 Antibody in Immunohistochemistry (Paraffin) (IHC (P))

Search
Proteintech
AMDHD1 Polyclonal Antibody
{{$productOrderCtrl.translations['antibody.pdp.commerceCard.promotion.promotions']}}
{{$productOrderCtrl.translations['antibody.pdp.commerceCard.promotion.viewpromo']}}
{{$productOrderCtrl.translations['antibody.pdp.commerceCard.promotion.promocode']}}: {{promo.promoCode}} {{promo.promoTitle}} {{promo.promoDescription}}. {{$productOrderCtrl.translations['antibody.pdp.commerceCard.promotion.learnmore']}}
产品信息
21171-1-AP
种属反应
宿主/亚型
分类
类型
抗原
偶联物
形式
浓度
规格
纯化类型
保存液
内含物
保存条件
运输条件
产品详细信息
Immunogen sequence: CILPGLVDAH THPVWAGERV HEFAMKLAGA TYMEIHQAGG GIHFTVERTR QATEEELFRS LQQRLQCMMR AGTTLVECKS GYGLDLETEL KMLRVIERAR RELDIGISAT YCGAHSVPKG KTATEAADDI INNHLPKLKE LGRNGEIHVD NIDVFCEKGV FDLDSTRRIL QRGKDIGLQI NFHGDELHPM KAAELGAELG AQAISHLEEV SDEGIVAMAT ARCSAILLPT TAYMLRLKQP RARKMLDEGV IVALGSDFNP NAYCFSMPMV MHLACVNMRM SMPEALAAAT INAAYALGKS HTHGSLEVGK QGDLIIINSS RWEHLIYQFG GHHELIEYVI AKGKLIYKT
靶标信息
AMDHD1 is a protein coding gene.
仅用于科研。不用于诊断过程。未经明确授权不得转售。
篇参考文献 (0)
生物信息学
蛋白别名: Amidohydrolase domain-containing protein 1; Probable imidazolonepropionase; unnamed protein product
基因别名: 1300019J08Rik; AMDHD1; HMFT1272
UniProt ID: (Human) Q96NU7, (Mouse) Q9DBA8
Entrez Gene ID: (Human) 144193, (Mouse) 71761